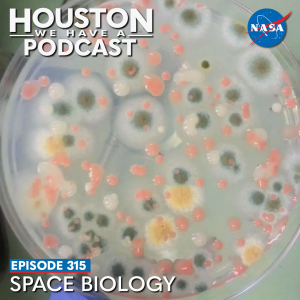

From Earth orbit to the Moon and Mars, explore the world of human spaceflight with NASA each week on the official podcast of the Johnson Space Center in Houston, Texas. Listen to in-depth conversations with the astronauts, scientists and engineers who make it possible.
On episode 315, NASA scientist Dr. Sharmila Bhattacharya describes how space biology research can contribute to significant scientific and technological advancements that not only enable space exploration for future long-duration space missions, but also benefits life on Earth. This episode was recorded on October 18, 2023.

Transcript
Host: (Gary Jordan): Houston, we have a podcast! Welcome to the official podcast of the NASA Johnson Space Center, Episode 316, “Space Biology.” I’m Gary Jordan. I’ll be your host today. On this podcast, we bring in the experts, scientists, engineers, astronauts, all to let you know what’s going on in the world of human spaceflight and more. We talk a lot on this podcast of flying humans in space for a better understanding of what happens to the human body and how it adapts from living in the comfort of one g, breathing fresh air and watching the sunrise and set once a day, to taking away gravity in a spacecraft with regenerative life support and 16 sunrises and sunsets in a day. It can be quite a change. So we investigate this adaptation, particularly in humans from many different perspectives, whether it be looking at vision, exercise, physiology, fluid shifts, and so on.
Many of the things we learn in space about the human body can also improve life on Earth. We can also get a better understanding of those basic mechanisms for adaptation from studying other living organisms in space, from bacteria and fungi to animals. Living organisms are used on Earth to model human disease, responding to stress and more in space. They can offer a unique window into answering some interesting questions to help us get a better understanding into this complex and fascinating world of space biology. We’re lucky to bring in Dr. Sharmila Bhattacharya, program scientist for Space Biology within the Biological and Physical Science Division at NASA’s Headquarters in Washington. A seasoned scientist, Sharmila has done research and developed hardware and payloads for supporting space shuttle, International Space Station, and even small satellites for decades. Alright, let’s get right into it.
[Music]
Host: Sharmila Bhattacharya, thank you so much for coming on Houston We Have a Podcast today.
Sharmila Bhattacharya: Thank you so much, Gary, for having me on this. I’m really excited to be on.
Host: You know, it’s funny, we were talking a little bit beforehand. You’ve been on my list of someone to talk to for quite some time. I remember for a while there, I was the International Space Station public affairs officer. There were some fruit fly experiments happening on station that would just super intrigue me. And just through a variety of circumstances, we couldn’t connect. But I’ve got to tell you, Sharmila, I am excited to be able to connect with you today. You’ve got some interesting stuff going on.
Sharmila Bhattacharya: Thank you, Gary. Yes, we sure do. You know, the fundamental research that we do in space biology, I think is intriguing, fascinating, and we learn a lot from these studies.

Host: Yes, exactly. And that’s precisely what I want to go into. I usually start though, Sharmila, with my guests by getting a sense of their background, and really what led you to where you are today. I wonder what in your life guided you to join NASA and perform all of these amazing studies? How did you end up where you are?
Sharmila Bhattacharya: Yeah, you know, that is really interesting, Gary, and I think something perhaps that happens to a lot of people where you don’t really know where life is going to lead you. And so, you know, the thing that I did know, from a very early stage, I really loved science and I really enjoyed doing science. So, you know, I was doing my graduate research, my PhD, at Princeton University and working on nothing related to spaceflight. I was using the yeast cell, you know, the same kind of yeast that you use to make, bread or beer, if you’re over the age of 21, hopefully. But it served as an extremely useful, model organism on Earth, for example, for looking at important questions like “how do cancer cells develop and grow?” and regulation of cancer-causing genes, how they function in cells and cause unregulated growth. So that was something that I was working on for my PhD and then for my postdoctoral research. And that’s when I moved to Stanford University and I started working on another, model organism, also important for fundamental research. And that was with the fruit fly, Drosophila melanogaster. And there, I was looking at the brain and how the brain functions, how the neurons talk to each other, you know, something that’s very important for us to understand for humans. But really for any biological system, multicellular biological system, that has a central nervous system. Again, nothing to do with space.
You know, this was the time when we still used newspapers to look for jobs or look at job ads. And so I was working on putting together a publication from the research I was doing in my postdoctoral fellowship and I happened to find an ad in the newspaper from NASA. And really, I had never thought of NASA and spaceflight research before, especially in the context of biology. And lo and behold, this particular advertisement asked for a PhD scientist who had worked with the yeast model and the Drosophila model for spaceflight research. Really, it stopped me dead in my tracks. And I thought to myself, “I would be a fool not to apply for something that was just so completely aligned with what I had done in the past.” And yeah, fast forward, you know, a few interviews and being hired by NASA. I have been at NASA now for over 24 years, conducting science and research and managing science and research for spaceflight work in the Space Biology Program.
Host: Unbelievable. Yeah. It’s like that ad had Sharmila at the beginning of it. “Hey, Sharmila, we’re looking for someone with a background who has done research with yeast.” You know, like it was calling to you specifically. What a wonderful time to open up the newspaper. And it just so happened to be right there.
Sharmila Bhattacharya: Exactly.
Host: You know, one thing you mentioned in the very beginning, Sharmila, was you said you were always interested in science. And I wonder if we backtrack even further, where that might have sparked, if you opened up a Christmas present and there was a mini-laboratory, like a play laboratory set. Maybe was there something early in your childhood that really started you off in the right direction to really love science?
Sharmila Bhattacharya: Yeah, you know, that’s a great question, Gary, because, to be honest, I also loved English. I loved writing. I loved history, and I loved all the sciences and I loved math. So really, you are right that at some point, it must have been a bit of a struggle for me to figure out what I really wanted to pursue later in life. And I’ll tell you, now that I think back, now that you’re asking, you know, what were some of those influences that might have kind of nudged me along the path that I did eventually choose? And I think it was a combination of factors.
One, I had a really dynamic and enthusiastic and fabulous biology teacher in middle school and high school. They were motivating. They were enthusiastic themselves. And I remember that well certainly. I also remember we had a biology textbook in middle school, I remember in sixth grade. And actually, even today, I remember images from that book. It was really well-written, with beautiful images in it. And I remember even the diagram of the inner ear and how, how the inner ear functions. And, you know, fast forward many, many decades later, how the inner year functions is very important to NASA, you know, because, an astronaut, when you’re in spaceflight, your orientation of how you orient to gravity is actually determined by the functioning of your inner ear, right? And again, you know, just those little things that fall into place, you know, I remember loving that chapter, and because it was something I had never imagined that something in your ear actually helped you understand, you know, your orientation with respect to gravity, so that when you’re about to fall, you know, you can right yourself and it’s because of this vestibular function in an ear. So, I think it was that it was my parents, you know, who were, awesome in terms of supporting my love of science. Neither of them were scientists. My mother was an English literature major, and my father was an economics major and then he went on to be a pilot. So of course, he loved the skies. But, other than that, and my brother was in English literature and economics major, so I guess I was the odd one out in the family, but my family loved that and encouraged me. So I think it was a combination of all these factors, possibly, that led me in this direction.
Host: Yeah. The inspiration and the support structure to point you in the right direction. I’ve got to tell you, it’s make or break with the teachers. I remember one year, I think it was ninth grade for me, I was in biology, and that teacher, I remember putting slides of textbook chapters onto a projector and sitting there silently while we copied what was on the chapters. As interesting as biology was, that particular teacher did not inspire me, where the next year I remember sitting in a chemistry class, and day one, instead of opening up a textbook, we went to the back of the class into the laboratory and she put down these different chemicals and was lighting the desk on fire. And I’m like, “Okay, now I’m in the right science field,” it can really truly make or break your experience in what you end up pursuing. And I remember being seriously interested in biology but turned more towards chemistry at least. And obviously, I didn’t end up pursuing it. You know, as interested as I was, I couldn’t quite grasp the material as well as some of my colleagues and other students. But I tell you, it was so different. It is so great to have a teacher that can inspire you.
Sharmila Bhattacharya: Absolutely. Absolutely.
Host: Now, Sharmila, you said you have been at NASA for 24 years doing a variety of things. I wonder where you started, and if you could tell us about some of the research that you’ve done over the years and over time to get you where you are today. And we’re going to talk about BPS, Biological and Physical Sciences where you are now, but I wonder, your career progression at NASA through those 24 years that got you and some of the highlights along the way.
Sharmila Bhattacharya: Yes, sure. So, you know, it’s been an interesting ride and continues to be an interesting ride for me because you really, every turn and bend, you learn something new, something exciting is happening around you. Either you are part of that exciting journey, or you’re listening to your colleagues who are part of those other varied stories about folks bringing back regolith from an asteroid, you know, that has never been done before. Or, you know, landing a craft on the surface of Mars, right? So there’s always excitement around you.
So in my particular case, over the years, I have worked with a variety of different experiments. And to be honest with you, Gary, some of them, I’m probably not even remembering right now, after having been here for many years as I have. But for example, I’ve worked on experiments to do with the brain, understanding how the brain functions, how that can alter in spaceflight. I’ve worked with using simple organisms like the yeast, as we talked about before, it’s a unicellular system. It’s what’s called a eukaryotic cell, though. So it’s cell structure, cellular structure is actually very similar to our cells. You know, the human cells are mammalian cells. So we can learn a lot from some of those simple experiments. I’ve also worked with experiments with drosophila melanogaster, the fruit fly, which is multicellular, but also simple and robust. Its genetics are extremely well characterized. So that helps us understand different molecular pathways that are important in the body when you are put in this unique environment of space. I’ve also worked with experiments to do with Mammalian cells in culture, in tissue culture and petri dishes and understanding how they function. So a wide variety, you know, as well as other animal studies with other model systems like rodents, et cetera.
All of them are really important in understanding this spaceflight environment, with its unique features that we don’t typically experience on Earth, for example, you could be in an environment with no gravity. You know, when you are in orbital flight on your way to the Moon or on the way to Mars, you will essentially be experiencing very little to no gravity. And all of us, you know, all of us Earth-based biological systems, we have evolved over centuries, very, very long time to exist in an Earth’s one G gravitational field. So that’s one big difference. And then when you’re on the surface of the Moon, when you get there, when you land, or you’re on the surface of Mars, you impartial gravity, or in fractional gravity where your gravity is less than one G. But it’s more than the microgravity you were in when you were on your way to the Moon or Mars. So, you know, that novel environment of either partial gravity or very little gravity.
Sharmila Bhattacharya: There are many other factors, but one of them, for example, is additionally radiation, right? So there’s radiation coming from the Sun. There’s radiation around you in this galactic, cosmic environment, which is different and is definitely a little bit higher than what you would experience if you were either on the Earth’s surface, where it’s the lowest—and we’re the most protected on the Earth’s surface—but as you go higher above the Earth’s surface, you get increasing levels of exposure to these different types of space radiation.
So, you know, a combination of these factors as well as being in an enclosed environment gives you, for example, an elevation in carbon dioxide. When you’re in any kind of an enclosed space with a lot of people breathing around you, as we find when, for example, in an aircraft, before they turn on the air circulation for little bits of time there, carbon dioxide can really build up in those environments. And it can be the same in these enclosed habitats and space. And so, with all of that in mind, right, we’re talking about a unique environment. What we really need to understand, because we want to make sure that our crew members that go to these environments are comfortable, they take with them what they need in terms of countermeasures, medicines, anything that we need when we go on travel, right to different places, to make sure that we acclimate and adapt to those environments, that’s what we need to ensure. And that’s where space biology comes in, is really understanding the fundamental changes in the body, making sure that we have a grasp, and we can anticipate all of those changes and that we can take with us what we need in order to ensure that we’re comfortable on our journey.
Host: So this might help digest this a little, Sharmila, you know, on this podcast, we’ve had a number of folks from human research on to talk about that, which of course you’re talking about how humans react to the space environment and samples are a huge part of that, right? We talk about saliva, blood, we talk about urine, and these different ways of measuring changes over time that happen to the human body. What perspective, when we talk about model organisms to add that to the portfolio of our understanding, how does that round out our perspective a little bit better on how adaptation works in space?
Sharmila Bhattacharya: Yeah, exactly. Excellent question. So, yes, I mean, think about it, when we use humans as subjects for our study, which we actually do all the time, exactly like you mentioned, you know, humans are one of our most interesting in one of our primary model organisms, if you please, for studies in space, because we really want to understand what’s going on there. However, think about the limitations there, right? As you just mentioned, you can only collect samples such as saliva, urine, take swabs from the surface of the skin, maybe some flakes of skin or hair that come loose, et cetera, et cetera. So there’s a limit as to what kind of samples you can collect from the human. Now, nonetheless, you know, blood, et cetera, you do get very valuable information from all of those samples.
But now think about the fact that when you fly a cohort of crew, maybe you have four, if you’re lucky, you have four or a couple more people going on a particular mission, right? These four people, for example, that are going on this mission, that is the same duration, that have experienced the same sort of launch experiences and gravity changes during launch and during their stay and during return. So they have a common experience. But just think about the fact that there are only four human beings, if you’re lucky, undergoing that experience. And those four people are probably as different as you and I are different in terms of, you know, height, our genetic makeup, how our bodies react in stressful environments, how strong our immune systems are in order to counter an infection, some kind of a microbial infection that we may face, right? So the fact is that we can be extremely varied unless you and I were twins, which we are not. And even within twins, you know, there are some major differences. As you can tell, those of us who know twins, especially because very often they are fraternal twins, which means that they can be just as similar or as different as any brothers or sisters can be to each other.
Sharmila Bhattacharya: So the advantage of using some of these model organisms is that you can get a population, often a very large population of genetically identical organisms. I mean, take fruit flies, right? In a little breadbox size experiment, which is things that we have flown in the past, that I have flown in the past to do science, I can have literally thousands of flies go into space, breed, and then give me that next generation from which I can get extensive data about how their brain functioned, how their heart functioned, how their immune system functioned, right? And I can correlate all of that and say, “Okay, you know, when I integrate all of this information from thousands of animals, these are the subtle changes I see.” Right? And that’s the other point that I wanted to make is the subtlety of changes, right?
Now, we know that humans have gone into space and come back perfectly safe, right? We’ve gone to the Moon during the Apollo years, but for a very short period of time, relatively speaking. However, on the International Space Station, we have had crew there for even over a year sometimes, right? So for pretty long stretches of time, and they do their job and they come back. So, however, we also know that they undergo changes. You know, they definitely face differences in the spaceflight environment. And so we also know that some of these changes can be quite subtle.
So when you’re looking for subtle changes, that’s where the statistics and the population size become important. Because if you can have thousands of identical organisms on which to do your scientific research to see how the biology is functioning, then you can really be sure that these are indeed the changes that we’re seeing; because maybe you’ll see a 20% change in some particular bodily function in your heart, cardiovascular function or immune function, right? But you will not see that change. You will not be able to register that change if you use four different human beings, some males, some females, some who are 40 years old, others maybe who are 30 or 50, right? So all of these factors make a difference in science, and it’s all about reliability of your data, reproducibility of your data. And that’s where model organisms can really help us.
Host: Amazing, Sharmila. To get an even better understanding, I want to drill down for a second to see if—and maybe this is putting you on the spot—but I just wonder if, as you said, you’ve had a lot of experience just at NASA, and even before NASA, but really at NASA working with a lot of model organisms and these studies over time. I wonder if you can recall maybe it’s a moment, or maybe some particular instance where maybe something that you were observing surprised you or maybe something you were observing over time confirmed a hypothesis you got. I wonder if you can take us to a moment in time and reflect on something that kind of pushed our understanding of what happens to the human body and what happens to living organisms in space that took us a step further and something that excited you in a moment.
Sharmila Bhattacharya: Yes, absolutely, Gary. So let me give you two examples. Just because science can be so exciting. And because the spaceflight environment is so novel, a lot of what we learned from there is just so intriguing and interesting and different, that it’s hard for me to limit it to one. So let me give you two examples from my personal experience that I found to be interesting, exciting, and rewarding at the same time.
So one of the studies that I did with my team and remember in all of this, you know, the teams that we work on are absolutely critical. Especially science is a team sport. None of us do this alone. So, I’ve worked always with postdoctoral fellows and students and young research scientists and more experienced research scientists and colleagues, right? This makes it all the more exciting because as you discussed the results, you sort of really help each other grow in your understanding of the data that you’re looking at. So, the first example I wanted to give is we did this study using a bacteria called Serratia marcescens which is an important pathogenic bacteria for humans as well in terms of in hospitals, for example, where you have immune compromised patients. These Serratia marcescens are what is called opportunistic pathogens. So they kind of take hold in folks who are unable to counter their infections in the body. And so this is something that’s important for us to understand. And so, you know, the spaceflight environment, being a stressful environment for biological systems, we wanted to see what happens to Serratia marcescens when they’re exposed to the spaceflight environment. And what we found was that when we took Serratia to spaceflight, let them grow for a few generations, and then brought them back—and the fruit fly, again, for the reasons we talked about, you can infect a lot of fruit flies with the Serratia marcescens bacteria, and then really do a very thorough statistical measurement of the virulence factor or the pathogenicity factor on model organism like the fruit fly, which is also a host that is infected by Serratia just like humans are—and so when we brought this Serratia back from flight and we infected fruit flies with it, we found that there was definitely increased pathogenicity and virulence from these infections with only with the space form bacteria, you know, compared to the ground control that had never gone to space, there was a marked increase in pathogenicity.
Sharmila Bhattacharya: And so, you know, again, being a scientist and a molecular biologist, I wanted to get to the bottom line of what is happening, what is causing this, right? And the basic understanding as we know it today. So I’ll tell you exactly what we got to understand, what is the basis of that? But before I say that, let me set the stage by saying that we think that it could be that there are different mechanisms for different microbial systems of how they may change in their virulence or pathogenicity in these different stressful environments. So for Serratia specifically that we were studying, we wanted to really understand what’s going on. And did this really thorough study in our team where we started to look at what are some of those genes whose expressions are changing. What are some of those molecular pathways inside the body? Well, in this case, we should say inside the cell of these Serratia bacterial cells that are making them more virulent to the fruit fly host. And what we found was actually that it was an increased efficiency or effectiveness of utilization of this amino acid called asparagine. And now, what do I mean by all of this?
So, asparagine is an amino acid. We take in amino acids often in our diet and asparagine plays a very important role in forming many different cellular proteins inside the cells, not only in human cells but also in bacterial and other cells. And so it was this efficiency of utilizing this amino acid asparagine inside the cell that we think made the difference. And so we did lots of different assays and experiments. And as you were saying, you were interested in chemistry, a lot of these biochemical assays to understand, you know, how are the bacteria beginning to utilize asparagine more effectively than, for example, the host cells, right? And so they’re able to uptake and utilize this important amino acid in very effective ways, which are helping their cells grow at the expense of the host cells, which surround it. Long story short, we kind of got to the basic molecular underpinnings of why we think the bacteria was doing so well. And basically, the idea is that in spaceflight, that stress triggered the bacteria to turn on this pathway that was more efficiently utilizing this asparagine that gave it a survival advantage, essentially, in comparison to other cells that had not experienced this particular stress environment. So that was exciting, right? When you can really drill down to the basics of what some of those changes are. So that was number one.
Host: Yeah. What you’re talking about here is you said you addressed this, and in terms of what round perspective model organisms can provide. I think the word you used was subtlety, right? So this was a sort of an example of exactly that. It’s like a needle in the haystack. Like, what is making this thing spread so much? And it drills down to a very specific amino acid. Exactly. So this is an example of what you were talking about. Perfect.
Sharmila Bhattacharya: Absolutely, absolutely.
Host: Awesome. Alright. Example number two. Sorry to cut you off.
Sharmila Bhattacharya: Yeah, no, no, Gary. So example number two, again, a very different example. Cause now I’m going to talk about a multicellular system. I’ll talk about the fruit fly and I’ll talk about the brain, right? The central nervous system, the brain, the brain that we all have as humans, and something that’s critical to our performance, right? And everything that we do on a daily basis. So, again, the fruit fly is simple, though it may be, and though it may be something that you consider to be a pest or a menace when you see it in your kitchen. And remember, fruit flies are much smaller than the house flies that you usually see in your house. Fruit flies are those little tiny flies that will buzz around, running bananas or you’ll see it, you know, near garbage dumps, et cetera.
But again, they serve as very important and have served for decades actually, in science as a very important model organism. So they have a brain, actually a brain that’s extremely well studied. The fact that these model organisms are so well studied, and well characterized, their genetics are very well understood, really helps us. So the second example I wanted to give is that we did this experiment on the International Space Station. Actually, both the examples that I gave you, the first one with the virulence and the bacteria and this one were both done on the International Space Station, which has served as a very effective research platform over the last several years. And so with this second experiment with the fruit flies, we were very fortunate to be able to fly it on a particular hardware called the MVP, the Multi-Variable Gravity Platform, which has two compartments, it has two different centrifuges, and you can vary the gravity level that your samples are on in these two centrifuges. So this particular hardware piece had a compartment that we used with a one G setting. These are all identical samples coming from being bred by a common set of parents. And so these are identical fruit flies that we’re talking. So we can really compare the data sets. So one-third of them were put in a centrifuge that was rotating at Earth’s one G in space. Another one-third was put in microgravity in the other compartment of this hardware, where it was not spinning. So it was experiencing the microgravity environment. It was just slowly spinning every once in a while, just to make sure you were equilibrating the environment the atmospheric air, and all of that inside. But for the most part, it was not experiencing, any gravity. So the samples were in what is called microgravity. And then one-third of the samples were on Earth in an Earth gravity environment, not spinning and just being in that same identical hardware configuration, but on the ground as a control.
What we found was something very, very interesting. We were interested in the brain like I said, and the changes that we would see in the brain. So we now had three sample sets that we were comparing. We were looking at samples in space that were artificially given Earth’s one g. We had samples in space that were not experiencing any g like you would when you were in space. And then we had samples on the ground. So what we found when we came back down to Earth is that the samples that were in space in one g and the samples on the ground that had been one g were very similar to each other.
Sharmila Bhattacharya: But the samples that had been in space and microgravity, you know, had a lot more changes and defects seen in the brain compared to either the spaceflight one g or the Earth’s one g. Right? So what that meant is that in terms of neuronal changes and function, having that centrifugation, and giving that artificial simulated one g environment in space was very helpful. Now, fast forward, and this is again, where model organisms come in because in another month, those flies that came back from space had aged considerably. I mean, if you think about the fact that a fruit fly under very normal healthy conditions lives about, you know, two months-ish. So when you bring those flies back that are several weeks old already, you know, they’ve developed in space, they’ve grown in space, you bring them back a few weeks old, now you age them for another month. Now you’re talking about really pretty advanced senior citizens in terms of fruit flies. So what was really interesting is now when you did a comparison with these aged animals, and you compared the space-flown flies were exposed to one G and the microgravity-exposed flies and the Earth’s one g control flies. Now, you saw some differences, and when I say that, what do I mean? What we found is that the microgravity exposed flies after they were aged, they came back to Earth, they were treated it normally like all the other flies. But now what you’ve found is that yes, the microgravity-exposed fly still had the most amount of these changes in neuronal structure and function. But now the space flow, one g flies actually had more changes and differences compared to the Earth one g control flies that had never gone to space.
So what do we think is happening? So, you know, one of the things that really excited us is, one, it gave us many, many important pieces of information. One, it told us that artificial gravity can serve as an effective countermeasure, especially for those immediate changes that you see after spaceflight. However, just like experiences that one has, you know, if one has a viral infection on Earth sometimes, or you know, you’ve heard of long COVID, right? You know, folks get a COVID infection. And then in some people, there can be long-term changes and effects, right? So similarly, just like these unique changes and environments can impact us on Earth. Similarly, what we think is happening perhaps, is that these flies that we’re exposed to spaceflight, yes, the artificial gravity definitely helped with some of those short-term changes. But there are probably some other changes.
For example, a combination of other stressors like radiation, as we talked about. And you know, there’s elevated carbon dioxide buildup. We also talked about that. Combinations of these other stressors might actually result in some other changes that persist and get manifested in these long-term assessments that we do, right? Now, the good news is once, like we said earlier, with these model systems, once you understand it, you are in a better place than to go back and say, “Okay, so we know what we can do to help with some of these short term changes in these particular organ systems. Now let’s go back and think about how do we shield these organisms or the crew, et cetera, in a way that’s effective so that we reduce the impact of radiation, et cetera, et cetera?” Right? And that’s the function of research is one, understanding what are some of these changes, short-term, long-term, and then what do we do about them?
Host: Yeah. The solutions to solving the problems that you’ve identified through that research, it’s wonderful. And that’s such a good example cause it’s so holistic with all those different ways of analyzing the model organisms. Absolutely fascinating research, Sharmila and it’s a lot of work, I understand, to be able to design an experiment and come up with an idea, pitch that idea, and then fly it and get to those results. So, you know, when you talk about these things that you’re finding, I can only imagine the excitement that you were experiencing after so long of finding out what we’re going to do and how we’re going to solve some of these issues. And then having a better understanding through that research on the back end, thinking like, “Man, all that blood and sweat that I put in, all the long hours that I put into the research was worth it because we just advanced our understanding of what happens in space.”
Sharmila Bhattacharya: Exactly. You hit the nail on the head there, Gary.
Host: We’ve zoomed in now to a couple of examples. Zooming back out for just a second to understand you’re part of an organization at NASA called BPS, Biological and Physical Sciences. Yeah. It’s in the name, right? You have the biological, you have the physical, I think you are more on the biological. As part of your work as part of what you do today, now at NASA, within BPS, how would you describe your role in enabling biological science?
Sharmila Bhattacharya: Yes. So I’m the program scientist for space biology in the Biological and Physical Sciences Division at NASA Headquarters. So, as such, I’m responsible for the strategic planning and management of all of the space biology, science research that we fund from NASA. As I mentioned before, of course, we do this with the help of a lot of wonderful people within our space biology team.
Host: And so we’ve talked a lot about your research and talked about model organisms, but if you were to take a holistic view of, you know, what is it? In space biology, what kinds of research are you covering? You know, does it go much broader than some of the examples that we’ve talked about already?
Sharmila Bhattacharya: Yes. And in fact, let me also broaden further to what Biological and Physical Sciences, what our division does overall. I would say that we examine phenomena under space, like conditions that help us better understand how these systems function in the novel environment of space. And this understanding really helps contribute to making significant scientific and technological advancements that not only enable space exploration for future long-duration human space exploration, but also benefits life on Earth. So that’s sort of the bigger picture of what Biological and Physical Sciences does in our division.
Then specifically, as you asked for space biology, yes, indeed. In fact, you know, I’ve given you a few examples of model systems and science that I have been involved in over the decades. However, really big picture for space biology is that we use a variety of different model systems. Some are, for example, you know, three-dimensional tissue systems, in Petri dishes or in what they call in vitro cultures. Or small little organoids, you know, little brains or little kidneys in a tissue dish, to understand how they are going to react to this novel environment. We use a variety of different model systems, and the questions we ask are also very varied, down to the molecular level, how does a gene and how does your DNA expression, how the genes, which are these little important units within your DNA, they code for proteins that do the function and RNA that do different functions in your body. How do these respond in the environment? Down from that to the large, big picture, holistic level of how do all the different organ systems in your body react and integrate, and how does the organism as a whole change and respond to the novel environment of space? So all of that.
Not only that, you know, we talked about microbial systems and plants. You know, plants are a very important part of all of this. Because on Earth, for example, we can’t function without having green around us, without having our solid, without smelling that flower. And not only is it important for us nutritionally, but they help us psychologically, right? And it’s going to be the same in space. We’re going where we go. And when we want to live sustainably, we’re going to need to have plants around us. So understanding plants, microbes, animal systems, all of this will be an important part of our journey back to the Moon and onto Mars.
Host: Absolutely. And that research is continuing constantly. Even now coming up, we’re recording this ahead of a cargo launch to the International Space Station, SpaceX CRS 29. There’s a lot of science going up there. Sharmila, you told me there are even a couple of Biological and Physical Science experiments, going up on this cargo mission. Can you tell me about some of those?
Sharmila Bhattacharya: Yes, absolutely. In fact, let me tell you a little bit about three different space biology experiments that are going up in SpaceX 29, and that we are very excited about. One of them is called PH06 and it is actually looking at a plant system and something that all of us can identify with very well. It’s actually a tomato plant, and we are going to be looking at wild-type and immune-deficient tomatoes, well tomato plants. And we’re actually going to be looking at their immune defense response and, and how this changes in spaceflight and comparing the wild type and the immune deficient genetic version of the tomato plants. So we’re really looking forward to that. That’s the first one.
Another one and I think these sort of work well to round off how we use different model systems to ask different questions. So the second one, which is called Bacterial Adhesion and Corrosion, this is a collaboration within our division, between the physical sciences and space biology. So it’s a nice example of, again, this holistic approach of how we can answer a lot of different questions with our experiments. And here for Bacterial Adhesion and Corrosion, or BAC as we call it, we are investigating the formation of biofilms. Biofilms are these tough, robust formations that bacteria will often have on different surfaces. You will see that, you know, in your home sometimes if some area hasn’t been cleaned too well, you know, you’ll form this black film on various surfaces. So that’s a biofilm. We are going to be looking at, in this particular experiment, the principal investigators are going to look at the formation of biofilm on different surfaces like stainless steel surfaces and how they form in space, as well as how different kinds of disinfectants might be able to help us clear the biofilms that are formed under these different conditions. So that’s the second experiment.
Then the third experiment, yet another model system asking yet a different question, which is called RR-20. This particular experiment uses the rodent model system to understand how there is a change in the estrogen receptor expression during spaceflight. We have evidence from past shuttle missions that there are changes in the expression of these estrogen receptors found in the body. And we’re going to use the rodent model to understand that because there’s a very important result here to be had, which is the estrogen receptor also can influence bone loss. Right? And so we want to, again, get to the basis of, we know that over a period of time in low gravity, bone density is lost, and we want to understand some of the causes of that. Looking at the expression of estrogen receptor can help us answer some of those questions to see if they maybe exacerbate bone loss in space. And so anyway, these are three different examples. You know, the tomato plant, bacterial biofilm formation, and then changes potentially in estrogen receptor and bone density changes in three different model systems that we are looking forward to flying in terms of space biology payloads on SpaceX 29.
Host: Yeah. It shows that rounds the different kinds of model organisms that you can use to answer different questions. And I think it’s just so representative of all the work that is done in space biology and what you do, Sharmila. I wanted to wrap up with sort of this idea is, you know, I think we’ve done a good job of stressing the importance of model organisms and what they bring in terms of our understanding to science and just broadening our perspective. I wonder though, as we’re looking ahead to an expansion, I’ll call it, of operations and science and what we can have possible for us in the future. You know, we’re talking potentially multiple commercial destinations with scientific facilities in low-Earth orbit. We’re expanding our presence to the Moon. There are a lot of places we’re going that I wonder from your perspective, have posed some unique and interesting questions from a space biology perspective that perhaps you’re looking forward to. Whether it’s continuing in low-Earth orbit, whether it’s on the Moon and beyond, some things that maybe you are looking forward to in the world of space biology.
Sharmila Bhattacharya: Absolutely. Yes. And I think that’s a really wonderful way to round off this discussion because, to answer your question, we are absolutely looking forward to having the commercial low-Earth orbit platform so we can continue the research that we have started and have learned a lot from the International Space Station. We need to be able to continue to do that because low-Earth orbit will continue to be more accessible. We’ll have probably more crew available to help us with our experiments. But then we’re going to need to understand, expand that research, extend it from low-Earth orbit to the lunar surface, and then just like we’re saying, we need to piggyback off everything we learn to help us with the next step. So what we learned on ISS is something we need to continue on those commercial low-Earth orbit platforms, and then we need to piggyback off what we learned from low-Earth orbit to the lunar surface. Because on the lunar surface, we’re going to have increased radiation levels. We’re going to have different complexions of radiation on the surface of the Moon. We’re going to have different gravity levels. We’re going to have partial gravity on the surface of the Moon. So very different from low-Earth orbit orbital platforms like the ISS or the commercial platforms. So we’re going to have to expand our knowledge to learn how those different environments will now function on biological systems. And then we’re going to have to do long-duration experiments on the Moon with these systems that we just talked about so that we can understand how we’re going to transition and do those two to three-year-long round trip missions to Mars. And then how we’re going to grow our plants and sustain those, you know, insects that are going to help pollinate our plants and how we are going to have crew there sustainably with those plants and with those microbial environments, you know, we all carry microbes on our bodies and in our bodies. We will be taking all of that with us. And how does that whole biological ecosystem function, you know, transitioning from low-Earth orbit to the lunar surface to Mars and on our way to and from Mars. And so, I think this is an inherent part and an important part of that science research journey, where we use what we’re learning at every step to expand and extend our horizons.
Host: Wonderfully said Sharmila. And, I mean, in general, the work that you’re talking about here, just, to me sounds so incredibly important. And just that rounding out that perspective of what happens is just a wonderful thing. And getting an insight into some of the things that you’ve learned just in general over time kind of makes me excited for only what we can learn in the future. So with that Sharmila Bhattacharya thank you so much for coming on Houston We Have a Podcast. This was so cool to be talking with you. I’m glad we finally were able to connect and wishing you and the team all the best of luck on some of the research coming up and all that we can learn when it comes to spaceflight and our understanding of biological systems. So thank you so much.
Sharmila Bhattacharya: Absolutely, Gary, it was a real pleasure speaking with you, and I hope our paths cross again in the future. And thank you so much for all the work that you do. I think it’s so important to tell the folks out there who may be interested or have never thought about spaceflight research about some of the things that go on here. That’s so exciting.
Host: Very, very cool. Well, thank you so much, Sharmila. I appreciate the time. Take care.
Sharmila Bhattacharya: Take care. Bye.
[Music]
Host: Hey, thanks for sticking around. Such a wonderful conversation with Sharmila. She brought a ton of energy to the conversation and I hope you enjoyed it and hope you learned something today. You can check nasa.gov for the latest happening across the agency and nasa.gov/iss for everything happening aboard the International Space Station. You can check out nasa.gov/podcasts to listen to any of the podcasts we have across the agency. You can also find us there in our full collection of episodes, which you can listen to in no particular order. Check out science.nasa.gov under Biological and Physical Sciences, and you can dig through papers under NASA’s Animal Biology Program and many of the other things they have within BPS, Biological and Physical Sciences.
On social media, you can check us out on the NASA Johnson Space Center pages of Facebook, X, and Instagram. You can use #AskNASA on your favorite platform to submit an idea for the show or ask a question, just make sure to mention it’s for us at Houston We Have a Podcast. This episode was recorded on October 18, 2023. Thanks to Will Flato, Dane Turner, Abby Graf, Jaden Jennings, Dominique Crespo, Destiny Duran, Melanie White Lyons, and Keara Mangan. And of course, thanks again to Dr. Sharmila Bhattacharya for taking the time to come on the show. Give us a rating and feedback on whatever platform you’re listening to us on and tell us what you think of our podcast. We’ll be back next week.





























